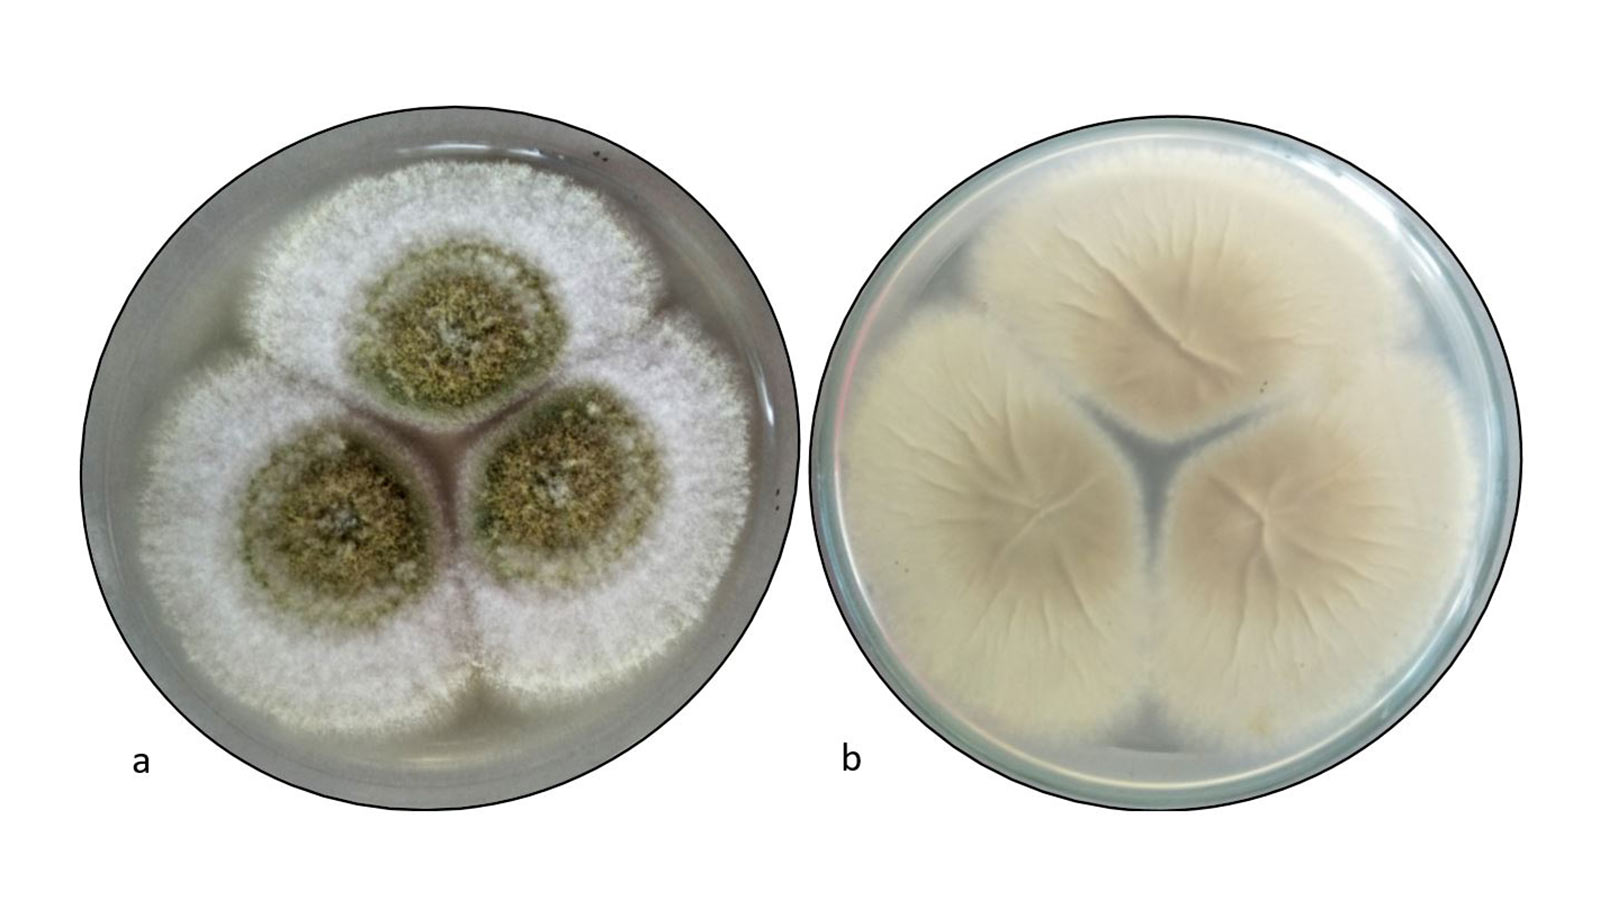
Fungus Once Feared as ‘Curse’ Could Transform Cancer Treatment

Cancer Treatment
-
Former MP Jody Wilson-Raybould Begins Breast Cancer Treatment, Urges Early Detection
Former federal justice minister and author Jody Wilson-Raybould has announced she is beginning treatment for breast cancer after recent surgery, urging the public to prioritize regular screenings. Her announcement comes as new research highlights advances in personalized breast cancer treatment.
-
Abiraterone: England Expands Access to Life-Extending Prostate Cancer Drug, Ending ‘Postcode Lottery’
Thousands of men in England with high-risk prostate cancer will now have access to the life-extending drug Abiraterone, previously limited by cost and regional disparities. This move, championed by patient advocates and charities, promises to save thousands of lives and…
-
Breakthroughs in Cancer Research
Cancer research has made significant strides, from AI-driven innovations to personalized treatments. Explore how breakthroughs in detection, treatment, and prevention are reshaping the fight against cancer.
-
Fungus Once Feared as ‘Curse’ Could Transform Cancer Treatment
Researchers have unlocked the potential of Aspergillus flavus, a fungus once linked to death, to develop a groundbreaking leukemia drug.
-
Immunotherapy Trial Offers New Hope for Cancer Patients
A groundbreaking immunotherapy trial shows potential to replace surgeries for certain cancer patients, preserving quality of life.